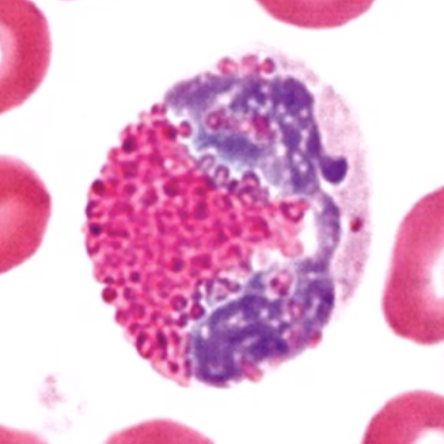

1
Q
acute inflammation
bacterial inflammation

A
Neutrophils
2
Q
allergic response
parasite infections
A
Eosinophils
3
Q
Chronic inflation responses

A
Basophils
4
Q
Acquired cellular immunity.
Viral infections
Cancer preventions.
A
Lymphocytes
5
Q
Chronic inflammation
Chronic infections
Enlarge, mature into macrophages

A
Monocytes
6
Q
- show up at the second response,
- live longest,
- cross placenta.
A
IgG

7
Q
primary responders,
short-lived,
first to be secreted by plasma antibodies.

A
IgM
8
Q
body secretions

A
IgA
9
Q
allergic reactions,
trigger mast cells.

A
IgE
10
Q

A
intercellular fluid
11
Q

A
intracellular fluid
12
Q

A
extracellular fluid
13
Q

A
Intra-vascular Fluid


